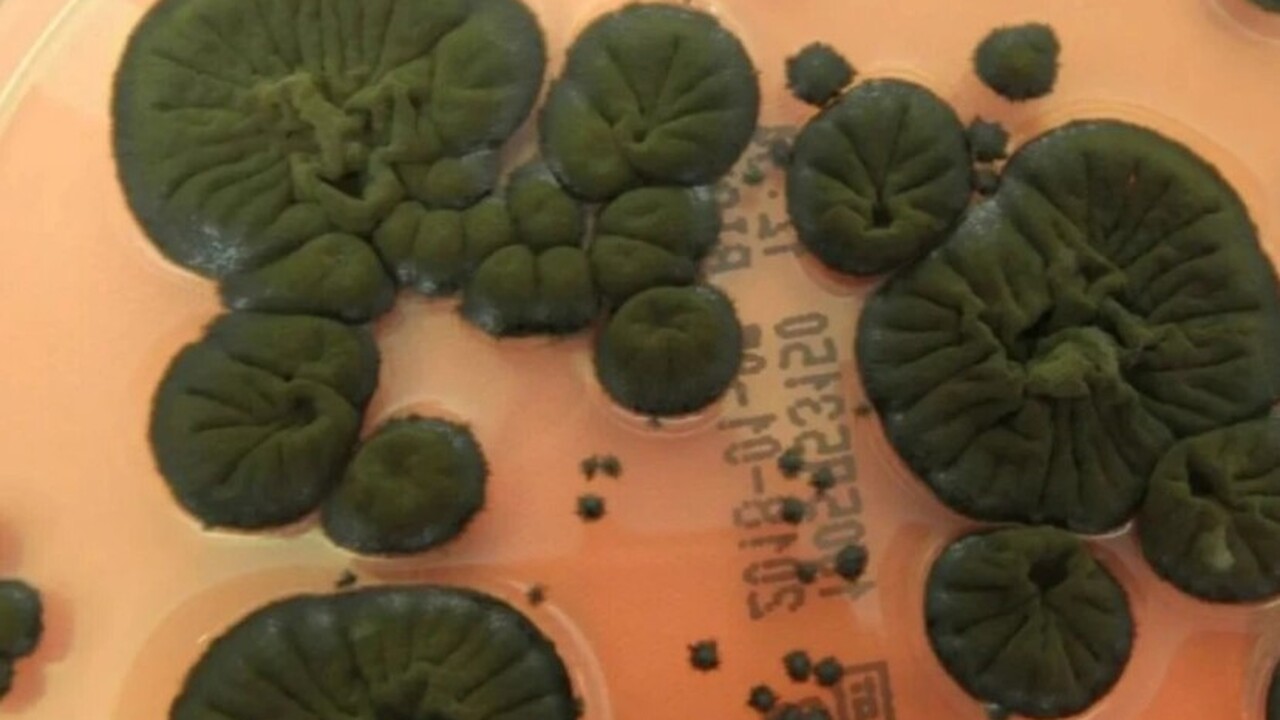
Проведено исследование: в Чернобыле найден черный гриб, питающийся радиацией В ходе комплексных исследований, проводимых в Ч...

Проведено исследование: в Чернобыле найден черный гриб, питающийся радиацией
фото: источник
В ходе комплексных исследований, проводимых в Чернобыльской зоне отчуждения, был выявлен уникальный биологический феномен — гриб Cladosporium sphaerospermum. Данный микроорганизм обнаружен на стенах разрушенного IV энергоблока Чернобыльской атомной электростанции, что представляет собой исключительный научный интерес ввиду экстремально высокого уровня радиационного фона в данной локации.
Cladosporium sphaerospermum привлек внимание научного сообщества благодаря своим выдающимся адаптационным свойствам. Предполагается, что клетки этого гриба содержат меланин, который способен абсорбировать энергию ионизирующего излучения и конвертировать её в метаболически доступную форму.
Хотя на данный момент не установлено, что Cladosporium способен осуществлять фотосинтез на основе радиационной энергии, экспериментальные данные свидетельствуют о том, что радиационное воздействие стимулирует его рост, а не оказывает ингибирующее или летальное действие. Этот факт противоречит традиционным биологическим реакциям на облучение, при которых клеточные структуры обычно подвергаются угнетению или деструкции.
Темноокрашенные представители рода Cladosporium были впервые идентифицированы в зоне отчуждения в конце 1990-х годов. Последующие исследования подтвердили их высокую радиационную устойчивость. Примечательно, что многие организмы, увеличивающие содержание меланина в ответ на радиационное воздействие, не демонстрируют активного роста. Однако Cladosporium sphaerospermum не только выживает в условиях экстремального радиационного фона, но и активно развивается, что свидетельствует о его уникальных адаптационных механизмах.
Эти открытия расширяют наши представления о биологических системах, способных функционировать в условиях высоких уровней ионизирующего излучения, и открывают новые перспективы для дальнейших исследований в области радиационной биологии и биотехнологий, пишет источник.


